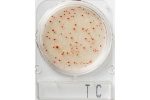

ATP Testi Nedir? Nasıl Yapılır?

Gıdalarımız Ne Kadar Güvenli?

İşletmeler İçin Hijyen Kontrolü Neden Önemlidir?

ATP Nedir?

Catering ve Toplu Tüketim Sektörü için Gıda Güvenliği Uygulamalarında Mikrobiyolojik Kontrol ve Lumitester Teknolojisinin Önemi
Nissui Compact Dry için on ikinci sertifika

Virüs Kontrolü için Temizlik Doğrulaması: Hijyen Görüntüleme Testleri

Covid-19 Virüs Ölçümü

Corona Virüs Ölçümü

Corona Virüs Ölçer

Covid-19 Virüs Ölçer

Covid-19 Hijyen Ölçümü

Covid-19 Dezenfeksiyon Ölçümü

Covid-19 Dezenfeksiyon

Tıbbi Cihazlar Virüs Ölçümü

Tıbbi Cihazlar Bakteri Ölçümü

Hastaneler İçin Bakteri Ölçüm Cihazı

Hastaneler İçin Virüs Ölçüm Cihazı

AMP Ölçüm Cihazı

ADP Ölçüm Cihazı

ATP Ölçüm Cihazı

Bakteri ve Virüs Ölçüm Cihazı Kampanyası

Hazır Besiyeri

Virüs ve Bakteri Kontrolü

ATP Hijyen Monitörü

Hijyen Kontrol Cihazı

Dezenfektan Kontrol Cihazı

Virüs Ölçüm Cihazı

Bakteri Ölçüm Cihazı

Corona Hijyen Ölçümü

Corona Dezenfeksiyon Ölçümü

Corona Dezenfeksiyon
Dilüsyon Sıvısı
- ANASAYFA
- KURUMSAL
- HAKKIMIZDA
- EĞİTİM ve DANIŞMANLIK
- HABERLER
- Corona Hijyen Ölçümü
- Corona Dezenfeksiyon
- Corona Dezenfeksiyon Ölçümü
- Dezenfektan Kontrol Cihazı
- Bakteri Ölçüm Cihazı
- Virüs Ölçüm Cihazı
- Hijyen Kontrol Cihazı
- ATP Hijyen Monitörü
- Virüs ve Bakteri Kontrolü
- Hazır Besiyeri
- ATP Ölçüm Cihazı
- ADP Ölçüm Cihazı
- AMP Ölçüm Cihazı
- Hastaneler İçin Virüs Ölçüm Cihazı
- Hastaneler İçin Bakteri Ölçüm Cihazı
- Tıbbi Cihazlar Virüs Ölçümü
- Tıbbi Cihazlar Bakteri Ölçümü
- TEMSİLCİLİKLER
- ÜRÜNLER
- VİDEOLAR
- BLOG
- İLETİŞİM







